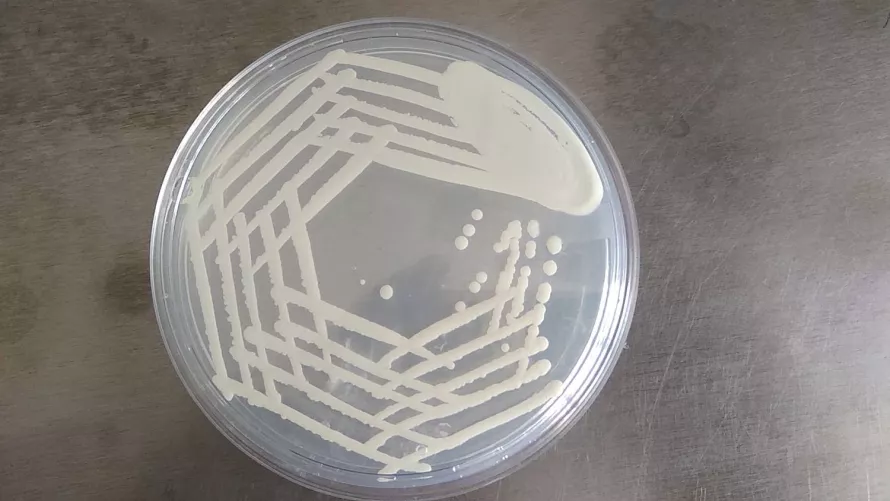
Candida telepek Petri-csésze táptalaján

A candida a sarjadzó gombák típusába tartozik, Albicans és non albicans típusú candidafajokat különböztetünk meg. 85-90 százalékban a Candida albicans okoz hüvelyi fertőzéseket. A candida gombáról tudni kell, hogy a normál hüvelyflóra 12 százalékban tartalmazza, tehát mindenkiben megtalálható. Ugyanígy a bélflórának és a szájflórának is része.
Panaszt csak abban az esetben okoz, ha valamilyen oknál fogva, pl. hosszan tartó betegség, antibiotikum- szedés, cukorbetegség kapcsán elszaporodik. Tehát a kórokozó elszaporodásában a gazdaszervezet csökkent védekezésének is alapvető szerepe van. A bőr- és nyálkahártya candidiásis kialakulásában a környezeti hatásoknak - mint pl. az izzadás, muszálas fehérnemu - is szerepük lehet.
A kialakult fertőzéseket, tehát az elszaporodott gombatelepek által okozott panaszokat is kezelni kell. A fertőzés tünetei: viszketés, égő érzés, folyás, fájdalmas vizelés. Férfiaknál a makkon okoz pici, piros, viszkető elváltozásokat. A candida fajok azonosítása morfológiai és biokémiai módszerekkel történhet.
A gomba többnyire a természetes hüvelykenetben felismerhető, néha azonban gombatenyésztést kell végezni. A diagnózis felállítását követően a kezelés viszonylag egyszeru: ma már számos gyógyszer áll rendelkezésre. A candidafertőzések kezelése igazán akkor hatásos, ha nemcsak helyi kezelést, hanem szájon át adható szisztémás kezelést is alkalmazunk. A gyógyszerek hatására a tünetek gyorsan elmúlnak, azonban komolyabb fertőzések esetén a betegség többször kiújul és több hónapig rendszeresen visszatér.
Ekkor mindenképpen javasolt a kezelést hat hónapig folytatni és betartani a megfelelő diétát. Mivel a candida erőteljesen szaporodik az élesztő és a szénhidrátok környezetében, emiatt a gyomor-, bélrendszerben elszaporodó gomba sokszor iszonyatos édességéhséget okoz.
A megfelelő diéta is segít
Szénhidrátot, tésztát és kenyérféléket ne fogyasszunk a kezelés ideje alatt. Együnk sok zöldséget, de a gyümölcsökkel is bánjunk csínján, mivel a gyümölcscukor is kedvez a candida szaporodásának. Diétázni egy hónapig kell, a megfelelő gyógyszeres kezeléssel kiegészítve. Ez általában hosszabb időre megszünteti a candidafertőzés tüneteit és kiújulását.
Dr. Szőczei Beáta
szülész-nőgyógyász
forrás: archívum
(Patika Tükör – 020801)